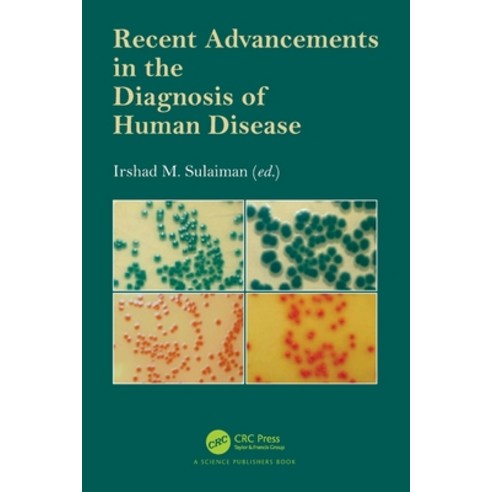
Product image

最近瀏覽商品
(英文圖書)Recent Advancements in the Diagnosis of Human Disease 平裝版, CRC Press, 英文
8%
$2,385
$2,385
酷澎售價
$2,185
首購折扣價

最高6折
已套用首購優惠券
4/1 預計送達
賣家:Coupang Global LLC
刷卡優惠

商品標示資訊
查看所有標示資訊查看更多
商品評價
酷澎上販售之同一商品的商品評價,商品賣家可能有所不同。
酷澎上販售之同一商品的商品評價,商品賣家可能有所不同。
沒有商品評價。
商品諮詢
- 購買的商品 取消/退貨請在我的酷澎購買記錄中申請。
- 商品咨詢及評價板塊不處理取消或退貨事宜,請聯絡客服中心。
- 價格、賣家、換貨/退貨及配送等與商品本身無關的咨詢請使用客服中心的1:1咨詢。
- 「商品本身」無關的內容、轉讓、廣告、辱罵、洗版等內容可能會被移動、隱藏或刪除。
- 請不要在公開的咨詢板塊中留下您的電話號碼、郵箱地址等個人資訊。
目前尚無咨詢。
如您發現商品有不實廣告、侵害智慧財產權或其他不適合銷售之情形,請提出檢舉







